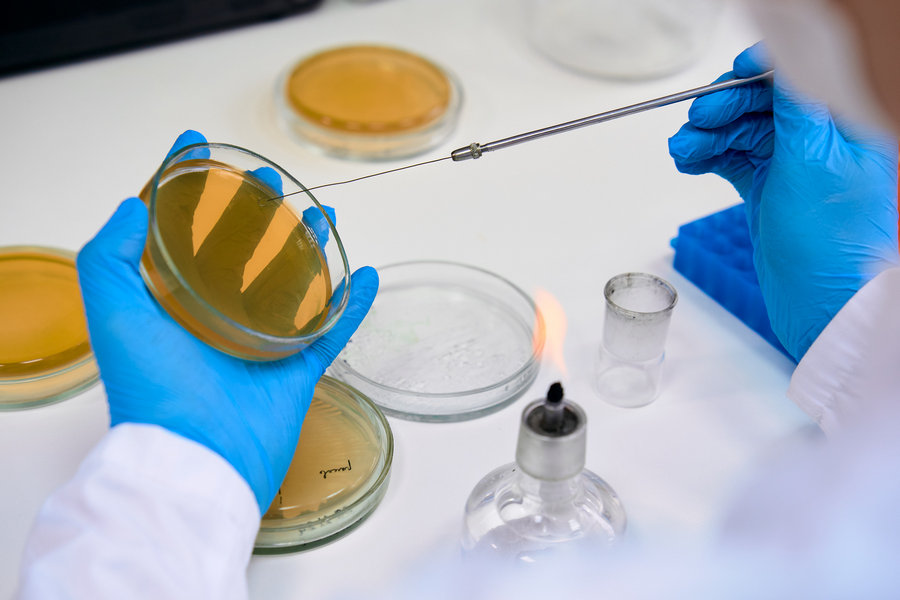
лаборатория ТМУ лаборатория ТМУ

В Тюменском медицинском университете (ТМУ) состоялось торжественное открытие Лаборатории метаболической и клеточной инженерии. Новая лаборатория станет площадкой для проведения фундаментальных и прикладных исследований в области биотехнологий, сфокусированных на разработке инновационных лекарств с использованием методов генной инженерии и культур клеток животных и растений.
Главная цель исследований – создание лекарств с высокой биодоступностью и минимальным риском побочных эффектов. Одним из ключевых направлений работы лаборатории станет разработка моноклональных антител – основы для лекарств против онкологических и орфанных (редких) заболеваний.
Ректор ТМУ Иван Петров подчеркнул, что лаборатория станет частью масштабного проекта по развитию биотехнологий в университете и регионе, тесно связанного с созданием Межуниверситетского кампуса. В кампусе планируется создать лабораторию фармацевтического скрининга, где разработки, начатые в новой лаборатории ТМУ, будут выведены на новый технологический уровень – этап создания конечного продукта и его коммерциализации.
Лаборатория оснащена современным высокоточным оборудованием, позволяющим проводить полный цикл исследований, от культивирования клеток до анализа качества получаемых продуктов. Здесь будут работать студенты и магистранты ТМУ, в том числе обучающиеся по новой программе магистратуры «Биотехнология».
Одним из первых проектов, реализуемых в новой лаборатории, станет «БиоТехФарма», направленный на получение биологически полноценных белков для пациентов с онкологическими заболеваниями. Ученые уже получили перспективный белок из клеток моркови и шпината, который поможет онкологическим больным восстановиться после химиотерапии.
Открытие Лаборатории метаболической и клеточной инженерии – значимый шаг в развитии медицинской науки и биотехнологий в России, открывающий новые перспективы в борьбе с тяжелыми заболеваниями.